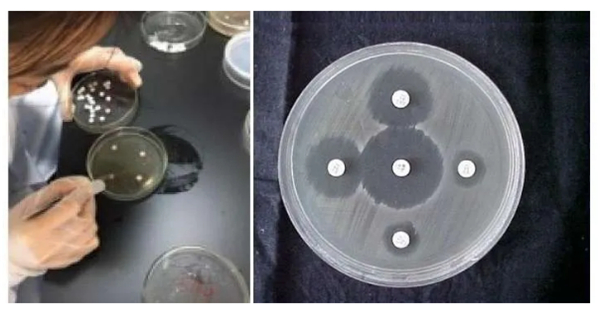

抗菌需求大
在畜禽养殖业,革兰氏阳性菌、革兰氏阴性菌、真菌和支原体、衣原体等非典型病原微生物造成的感染疾病,每时每刻都在发生和威胁着养殖业的健康发展。为了保障畜禽健康和养殖业效益,各种抗菌药物的使用就显得非常重要。所以,抗菌药是兽药市场上最大的一个兽药品类,也就当仁不让了。
抗菌作用
自从科学家成功开发出第一个抗菌药以来,人类至今已经开发和上市了一百多种抗菌药。这么多的抗菌药,按照药物分子结构特点和作用机制的相同或近似进行“分门别类”,现已被开发出来的所有抗菌药物,被科学家划分成了不同的药物类别。目前已经确定的抗菌药物类别总共有十五个大类,比如酰胺醇类(如氟苯尼考)、氨基糖苷类(如安普霉素)等。

那么,这么多的抗菌药,如若依抗菌药与病原菌相互作用的结果来划分,这十五大类抗菌药又可简化分为两类。一是常用剂量下,以杀灭细菌为抗菌结果的,即杀菌药;二是在常用剂量下,主要抑制细菌生长与繁殖为抗菌作用结果的,即抑菌药。由此,依抗菌药与病原菌的相互作用结果来分,抗菌药又可分为杀菌药和抑菌药两大类。
抑菌药物
通过上述讨论,我们知道了“依抗菌药与病原菌相互作用的结果”来分,所有已知的抗菌药可分为“抑菌药”和“杀菌药”两大类。那么,这种对抗菌药的二分法,如何理解呢?通俗的理解是这样子的,抑菌药就是抗菌药与病原菌这一对冤家之间,在对抗方面的作用结果表现为“势均力敌”。

因此,抑菌药对病原菌的作用不足以迅速将其彻底杀灭,它只能抑制体内已感染病原菌的繁殖、生长和扩大,从而降低或解除其对患病畜禽机体器官、组织等的损害,为感染动物机体自身免疫反应,以及清除病原菌至正常水平,赢得充分时间。从而,在疗程结束时,使机体对外整体表现为康复。
杀菌药物
前面一节我们讨论了抑菌药物,那么我们又如何去理解杀菌药物呢?顾名思义,咱们作为第三方评判:杀菌药物与病原菌治疗的PK,则杀菌药对病原菌的抗菌作用比较:杀菌药无论是在抗菌作用的强度方面,遇见敏感目标病原菌即杀灭;还是在其抗菌作用的效能方面,即抗菌作用的当量大小上,都对目标敏感病原菌具有绝对的优势。
即打个更形象的比喻,抑菌药就象战争中的步枪,打你还有还手、抵抗之力;杀菌药就像战争中的原子弹,打你没有还手之力。因此,杀菌药只要给予患病畜禽有效的剂量,在机体的组织、器官等病变部位达到有效作用浓度,则其对已感染、正在致病的病原菌是彻底的杀灭。那么站在这个角度理解这一类抗菌药物,就会发现:它们更适合急性细菌感染的、急症和重症疾病的治疗。
用药指导
前面章节,我们讨论了抗菌药按作用结果是抑制还是杀灭,可分为两大类“杀菌药”和“抑菌药”。又讲了,这两类分法对得到的两类抗菌药的理解。那么,这两类抗菌药——抑菌药与杀菌药,又分别有什么作用特点,对指导临床有效用药有什么意义呢?
对抑菌药来说,因为在说明指导使用剂量下,它对畜禽机体内病原菌的作用仅仅是抑制,所以此类抗菌药在体内维持“有效作用浓度的时间长短”,则与其在治疗临床应用的效果(即疗效),关系就大了去了(至关重要)。

也就是说,基层兽医或养殖场在治疗临床开具处方、指导药物用法时,就需要根据该类药物的作用特点,指导养殖户或饲养员要适当延长给药时间,选药要选择在体内保持有效血药浓度时间长的制剂。这样,才能确保好处方发挥出好疗效,帮助患病动物尽快康复。
那么我们再来看杀菌药,在标准说明或指导有效剂量下,其对敏感目标病原菌的作用是:遇见即彻底杀灭。而且,它的这种作用强度与机体病灶部位的药物浓度有直接的、线性的关系,即药物所能达到的有效浓度越高其抗菌作用的效能就越强。

因此,鉴于该类抗菌药物的作用强度与浓度之间的直接相关,而与其在体内的作用时间无关的这种抗菌作用特点,那么基层兽医师或驻场技术员在使用杀菌药物时,进行临床使用时,用药指导须要求饲养员和养殖户“集中给药”,这样才能充分发挥这类抗菌药物的作用效能,使患病动物尽快痊愈。


